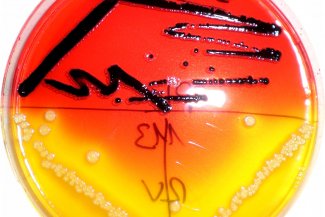

Kernkompetenzen
Die CPM Unternehmensberatung Lebensmittelsicherheit ist die Zentrale der Food Safety Senior Experts. Das mehr als 30-köpfige ExpertInnen-Team berät, auditiert, schult und entwickelt Unternehmen der Lebensmittelkette zu allen Themen, welche die Lebensmittelsicherheit beeinflussen. Kernbereiche sind die gesetzlichen Anforderungen und die Anforderungen der Managementsysteme für Lebensmittelsicherheit (IFS, BRC, FSSC, etc.), wie Risikomanagement / HACCP, Hygiene und Mikrobiologie, Allergene, Food Defense, Food Fraud und Lebensmittelsicherheitskultur. Weitere Themen sind z.B. Halal, Lieferkettensorgfalt, Nachhaltigkeit, Arbeitssicherheit, Energiemanagement, Digitalisierung, wenn diese sich mit den Anforderungen der Produktsicherheit überlappen. Unsere ExpertInnen erstellen auch Gutachten oder entwickeln Schulungsportfolios und E-Learnings zu allen Themen.
Mitglied seit …
01/2023
Gründungsjahr
2021 (Re-Gründung; Wurzeln im Jahr 1997)
Wir sind Mitglied, weil
… Lebensmittelsicherheit vom Dialog profitiert und nur im Miteinander wachsen kann.
Ansprechpartner
Dr. Andrea Dreusch
Direktorin
Tel.: 49 171 4948842
ab.dreusch@cp-management.de
CPM Unternehmensberatung Lebensmittelsicherheit
Grünwettersbacher Str. 12
76228 Karlsruhe
www.cp-management.de